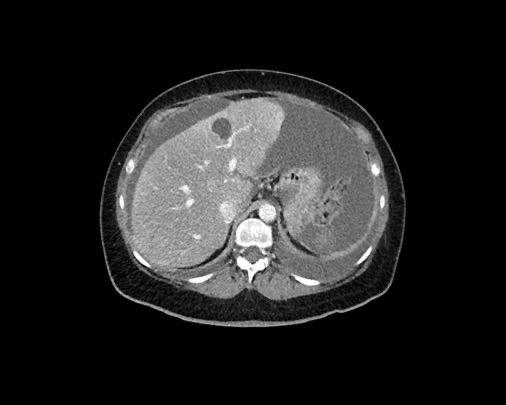
Slider image 1
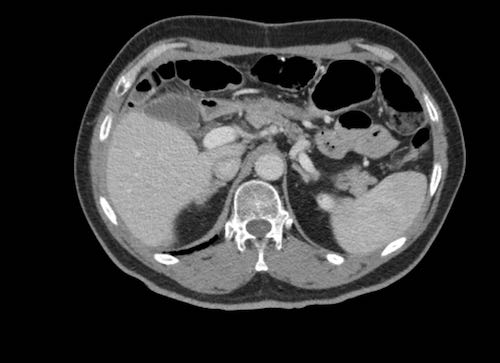
Slider image 5
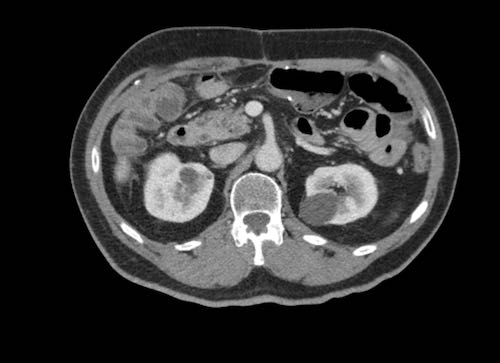
Slider image 8
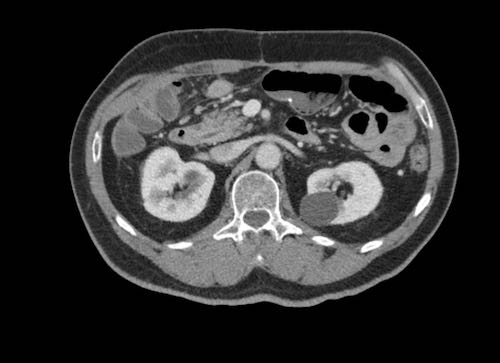
Slider image 9
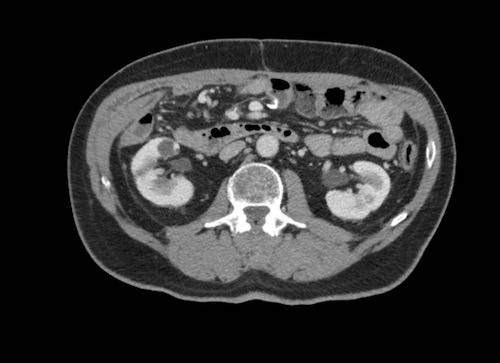
Slider image 12
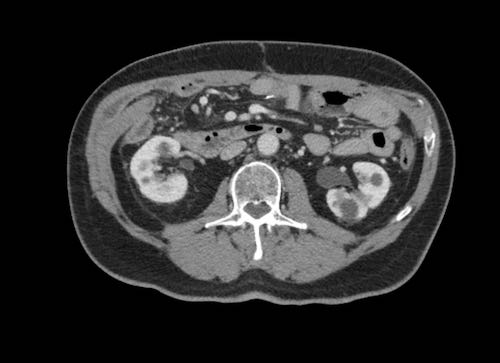
Slider image 13
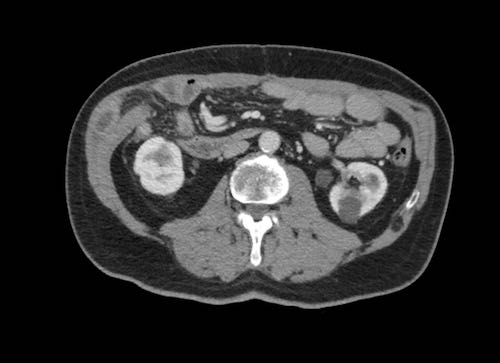
Slider image 14
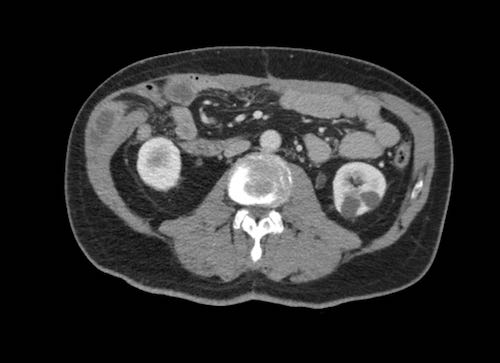
Slider image 15
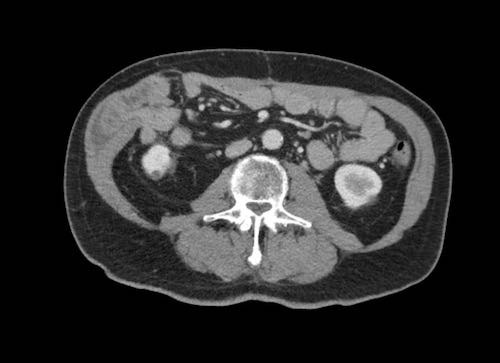
Slider image 16

Ung thư phúc mạc di căn
Trong bài viết này, chúng tôi mô tả những vùng trong ổ bụng cần được chú ý đặc biệt nhằm chẩn đoán ung thư biểu mô di căn phúc mạc và đánh giá mức độ lan rộng của bệnh.
Giới thiệu
Giải phẫu Phúc mạc
Phúc mạc gồm hai lớp.
Phúc mạc thành là lớp ngoài, bám vào thành bụng trước và sau (màu đỏ).
Phúc mạc tạng là lớp trong, bao phủ các tạng trong ổ bụng (màu xanh).
Mạc treo ruột có cấu trúc gồm hai lớp phúc mạc.
Mạc nối lớn là một nếp gấp lớn gồm bốn lớp phúc mạc tạng.
Nó trải dài thành hai lớp từ bờ cong lớn của dạ dày, đi xuống phía trước ruột non rồi gấp ngược lại để đi lên đến kết tràng ngang.
Mạc nối lớn bao gồm dây chằng vị-đại tràng, nối dạ dày với kết tràng ngang, và dây chằng vị-lách, nối dạ dày với lách.
Ung thư biểu mô phúc mạc di căn thường gặp nhất ở bệnh nhân ung thư buồng trứng, đại trực tràng, dạ dày và tụy, tuy nhiên hầu hết các khối u nguyên phát đều có thể biểu hiện dưới dạng ung thư biểu mô phúc mạc di căn (bảng).
Thể đồng thời của ung thư biểu mô phúc mạc di căn – ung thư nguyên phát và di căn phúc mạc xuất hiện cùng một lúc – khá phổ biến và đứng hàng thứ 5 trong các loại ung thư ở cả nam và nữ.
Thể không đồng thời – ung thư phúc mạc xuất hiện như bệnh tái phát sau phẫu thuật triệt căn ung thư nguyên phát – cũng khá phổ biến.
Vị trí cần tìm kiếm Ung thư Biểu mô Phúc mạc Di căn
Một số vùng giải phẫu đặc biệt có xu hướng là đích đến của các tế bào ung thư di căn phúc mạc.
Nguyên nhân là do dòng chảy theo chiều kim đồng hồ của dịch trong ổ bụng về mặt sinh lý, xuất phát từ sự thay đổi áp lực trong ổ bụng trong quá trình hô hấp.
Các tế bào khối u di chuyển theo dòng chảy này và bám vào phúc mạc dọc theo đường đi.
Dòng chảy theo chiều kim đồng hồ dọc theo:
- Túi cùng trực tràng-tử cung và trực tràng-bàng quang (túi cùng Douglas)
- Rãnh cạnh đại tràng phải
- Cơ hoành phải
- Dây chằng liềm
- Cơ hoành trái
- Rãnh cạnh đại tràng trái và trở về túi cùng Douglas
- Dòng chảy liên tục qua các nếp mạc treo ruột và xung quanh mạc nối.
Ở vùng bụng trên, cơ hoành và dây chằng liềm cần được chú ý đặc biệt.
Ở vùng bụng giữa, mạc nối, mạc treo ruột và rãnh cạnh đại tràng cần được chú ý.
Các tổn thương di căn mạc treo ruột có thể được quan sát rõ khi mạc treo được bao quanh bởi dịch cổ trướng.
Khi bệnh nhân có nhiều mỡ trong ổ bụng, các tổn thương di căn mạc treo ruột nổi bật trên nền mô mỡ xung quanh có tỷ trọng thấp.
Ở vùng chậu, vị trí quan trọng nhất là túi cùng trực tràng-tử cung và trực tràng-bàng quang (túi cùng Douglas).
Đôi khi có thể thấy di căn khối u lan ra phía trước bàng quang, nhưng không xâm lấn thành bàng quang, do bàng quang là cơ quan nằm ngoài phúc mạc.
Tuy nhiên, vòm bàng quang phía trên và ống niệu rốn được ngăn cách với khoang bụng bởi một lớp phúc mạc thành, tạo thành đích tiềm năng cho các tế bào khối u.
Đặc biệt khi bàng quang đầy, các tổn thương di căn phúc mạc có thể được quan sát thấy ở phía trước bàng quang, áp sát thành bụng trước.
Đây không phải là bệnh lý quanh bàng quang, vì khoang quanh bàng quang nằm ngoài phúc mạc và không thông với khoang trong phúc mạc.
Hình ảnh học
Cổ trướng
Sự hiện diện của cổ trướng là một dấu hiệu đáng lo ngại, do các nốt phúc mạc sản sinh ra dịch này và do đó có thể là gợi ý đầu tiên cho thấy ung thư phúc mạc (PC) đang hiện diện.
Hình ảnh
Hình ảnh siêu âm của một bệnh nhân nhập viện với cổ trướng (dấu hoa thị) cho thấy cả các nốt khối u trên phúc mạc thành (đầu mũi tên) lẫn một khối u lớn trên phúc mạc tạng (mũi tên trắng).
Dày mạc treo ruột
Cả siêu âm và CT đều có thể hiển thị hình ảnh dày các lớp phúc mạc của mạc treo ruột.
Đặc biệt khi có cổ trướng, hình ảnh mạc treo dày được ghi nhận rõ ràng trên cả hai phương thức chẩn đoán hình ảnh này.
Hình ảnh
Có một lượng nhỏ dịch cổ trướng.
Mạc treo ruột dày được quan sát thấy bám vào đoạn cuối của ruột non, hình ảnh điển hình của tổn thương xâm lấn mạc treo.
Hình ảnh này thuộc về một bệnh nhân khác nhập viện với cổ trướng.
Hình ảnh
Mạc treo ruột dày (dấu hoa thị) được quan sát thấy bám vào đoạn cuối của ruột non.
Đây là hình ảnh điển hình của tổn thương xâm lấn mạc treo trong ung thư phúc mạc.
Trên CT, hình ảnh dày mạc treo ruột cũng có thể được ghi nhận.
Hình ảnh
Các cấu trúc dạng tấm mỏng là hình ảnh mạc treo ruột dày nhẹ.
Ở đầu tận, một đoạn ruột non được gắn vào.
Trong trường hợp không có cổ trướng, sẽ không thể phát hiện được tình trạng dày tinh tế này.
Theo nguyên tắc chung, khả năng quan sát thấy mạc treo ruột là một dấu hiệu đáng lo ngại, đặc biệt khi có hình ảnh dạng nốt.
Trong trường hợp không có lượng lớn dịch cổ trướng, việc phát hiện tình trạng dày mạc treo ruột sẽ khó khăn hơn.
Cần tìm kiếm các tổn thương dạng nốt hoặc đường thẳng dày được bao quanh bởi mỡ ở phía mạc treo của ruột.
Hình ảnh
Hình ảnh CT của một bệnh nhân ung thư phúc mạc.
Một lượng nhỏ dịch cổ trướng hiện diện ở góc phần tư trước bên phải.
Các đường dày dạng nốt vuông góc với thành ruột được ghi nhận.
Hình ảnh này đại diện cho tổn thương xâm lấn mạc treo ruột lan rộng (mũi tên).
Mạc nối bánh
Mạc nối là một trong những cấu trúc trong ổ bụng đầu tiên bị xâm lấn bởi ung thư phúc mạc.
Hình ảnh gọi là “mạc nối bánh” (omental cake) là kết quả của các nốt khối u lan rộng trong mạc nối lớn.
Tổn thương này có hình ảnh rất điển hình trên cả siêu âm và CT.
Hình ảnh
Hình ảnh siêu âm của mạc nối bánh nổi trong dịch cổ trướng.
Mạc nối bị ung thư phúc mạc xâm lấn có dạng nốt và không đồng nhất so với mạc nối bình thường.
Hình ảnh
Hình ảnh CT của mạc nối bánh nổi trong dịch cổ trướng (mũi tên).
Mạc nối nằm ở bụng trái, trải dài từ bờ ngoài dạ dày xuống phía dưới.
Hình ảnh cho thấy cấu trúc dạng nốt không đồng nhất rõ rệt, điển hình của mạc nối bánh.
Các chấm trắng trong mạc nối có thể là các mạch máu.
Rãnh cạnh đại tràng
Bất kỳ vị trí nào trong ổ bụng được phủ bởi phúc mạc đều có thể là đích đến của các nốt cấy ghép phúc mạc.
Các vị trí điển hình khác bao gồm rãnh cạnh đại tràng, túi cùng trực tràng-bàng quang hoặc trực tràng-tử cung, dây chằng liềm và mặt bụng của cơ hoành.
Cơ hoành
Do tác động của hô hấp, các tế bào khối u tự do bị hút vào mặt bụng của cơ hoành.
Các nốt cấy ghép này thường bị đánh giá thấp hoặc bỏ sót trên các lát cắt axial và được ghi nhận rõ hơn nhiều trên các mặt phẳng coronal hoặc sagittal.
Trong trường hợp này, các nốt khối u hiện diện rõ ràng và bao phủ phúc mạc gan.
Cuộn xem ảnh CT
Ca lâm sàng 1
Cuộn qua các lát cắt.
Bạn có thể phát hiện tất cả các tổn thương cấy ghép phúc mạc không?
Bệnh nhân này đã được phẫu thuật và toàn bộ phúc mạc được ghi nhận phủ kín bởi các tổn thương u dạng kê.
Ca lâm sàng 2
Cuộn qua các lát cắt.
Bạn có thể phát hiện tất cả các tổn thương cấy ghép phúc mạc không?

.jpeg)











